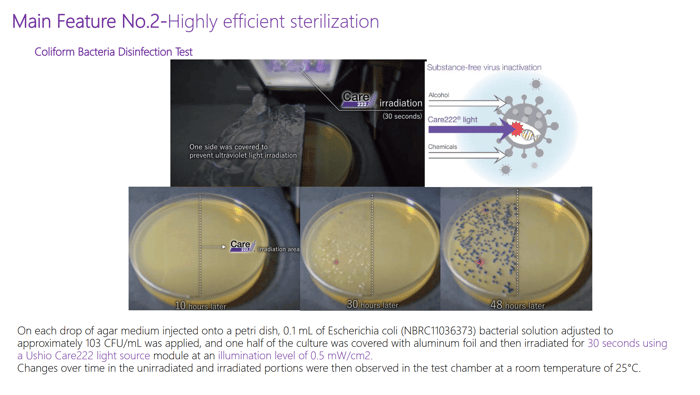

Table of Contents
- What is FarUVC 222 nm?
- What does it do?
- How does it work?
- How quickly does it work?
- Is it harmful to humans?
- What safety measures are in place?
- What evidence already exists to support its use?
- Where is FarUVC being used already?
- Where should I put a MySoter B2 device in a room?
- How many do I need in one room?
- Are they portable?
- How are they powered?
- What is the difference between the B2 device and the Car device?
- I don’t use the same vehicle all the time — is there a way I can easily transfer the FarUVC car device?
- Where can I find more information about MySoter products?
- Check out our Mysoter FarUVC products
- FAQs
What is FarUVC 222 nm?
FarUVC 222 nm is a specific wavelength of ultraviolet light produced by filtered excimer lamps. Unlike traditional germicidal UV, it has very limited penetration in biological tissue, which allows it to inactivate microbes while remaining suitable for use in occupied indoor environments when properly designed and certified.
What does it do?
Far-UVC light damages the genetic material of airborne viruses, bacteria, and spores, preventing them from reproducing and causing infection. In indoor spaces it acts like an invisible air disinfectant, continuously reducing microbial load as air circulates through the illuminated zone.
How does it work?
UVC light inactivates airborne pathogens primarily by damaging their genetic material so they can no longer replicate. When microbes suspended in air pass through UVC radiation, photons are absorbed by nucleic acids (DNA or RNA) and proteins.
This energy causes photochemical reactions—most importantly the formation of pyrimidine dimers(such as thymine dimers in DNA or uracil dimers in RNA). These lesions distort the genetic structure and block transcription and replication.
A virus or bacterium with enough of this damage cannot reproduce inside a host cell, so it is considered “inactivated,” even if its physical structure remains intact.

For airborne transmission specifically, the process is effective because microorganisms are exposed directly in tiny droplets or aerosols with minimal shielding.
Far-UVC (around 222 nm) works through the same nucleic-acid damage mechanism as conventional 254-nm UVC, but it is absorbed more strongly by biological materials. This means it penetrates only micrometres into tissue—enough to reach microbes (which are very small) but not deep enough to reach living human skin cells or the eye’s sensitive layers.

That differential penetration is what makes continuous disinfection of occupied air theoretically possible.
How quickly does it work?
Far-UVC begins inactivating microbes immediately upon exposure. Depending on airflow, room size, and output level, meaningful reductions in airborne pathogens can occur within minutes, with ongoing operation providing continuous suppression of transmission risk.

Is it harmful to humans?
Filtered 222 nm light is designed to be far safer for human exposure than conventional 254 nm UV-C because it cannot penetrate the outer dead skin layer or the tear film of the eye. However, exposure limits still apply, so certified devices are engineered to keep irradiance within international safety guidelines.

What safety measures are in place?
Modern Far-UVC devices typically include filtered lamps, calibrated output limits, exposure-compliant optics, and onboard sensors such as occupancy detection, tilt protection, and safety shutoffs. These features help ensure the device operates within recognized photobiological safety standards for occupied spaces.
What evidence already exists to support its use?
Far-UVC isn’t brand-new scientifically, but its use as a continuously operating hospital infection-control tool is new, and proving reductions in patient infections requires large, slow clinical trials that are only now maturing.
Orthopaedic operating rooms: A large comparative study (5980 joint replacements over 19 years) reported lower postoperative infection rates with UV lighting vs without. This is frequently cited in Far-UVC discussions, but it used traditional germicidal UV, not 222-nm Far-UVC.
https://pubmed.ncbi.nlm.nih.gov/17768189/
Far UVC specific:
Occupied-room airborne pathogen reduction (real occupied indoor location): Buonanno et al. (2024) quantified reductions in airborne infectious virus with 222-nm Far-UVC in an occupied setting (environmental transmission surrogate, not infections).
https://pmc.ncbi.nlm.nih.gov/articles/PMC10954628/?utm_source=chatgpt.com
Large dental clinic (Journal of Hospital Infection, 2026): Far-UVC installation in an occupied clinic; air sampling suggested an estimated ~40% reduction in airborne bacteria (again: environmental endpoint).
Supporting “bridge” evidence (mechanistic + safety, not infection rates)
These are often used to justify trials aimed at reducing HAIs, but they don’t themselves show fewer patient infections.
- Room-sized chamber work showing aerosol inactivation (e.g., S. aureus):
https://www.nature.com/articles/s41598-022-08462-z?utm_source=chatgpt.com
Systematic review/meta-analysis comparing 222 nm vs 254 nm efficacy & safety:
'Compared with 254-nm UVC, 222-nm UVC not only exhibits comparable or potentially superior efficacy in disinfecting diverse micro-organisms but also causes less DNA damage to the mammalian cells.'
https://www.sciencedirect.com/science/article/pii/S0195670125000921?utm_source=chatgpt.com
Where is FarUVC being used already?
Far-UVC technology is already being deployed in healthcare settings, laboratories, offices, public transport, hospitality venues, schools, and high-risk shared environments where reducing airborne infection risk is beneficial. Research trials and pilot installations continue worldwide.

Where should I put a MySoter B2 device in a room?
A B2 unit is typically most effective when mounted high on a wall or near ceiling height, with its front facing into the room. This placement allows it to disinfect circulating upper-room air while keeping exposure levels comfortable for occupants and avoiding blockage from furniture.
How many do I need in one room?
The number of units required depends on room size, ceiling height, ventilation rate, and occupancy. Small rooms may need only one device, while larger or densely occupied spaces may require multiple units spaced to ensure even coverage and sufficient air treatment.
Are they portable?
Yes. B2 units are designed to be relocatable and can be mounted or repositioned as needed. While they are not handheld devices, they can be moved between rooms or installations without permanent structural modification.

How are they powered?
The B2 device is powered via a standard mains outlet. The vehicle version is powered through the car’s electrical system, typically via a 12-volt accessory outlet or integrated vehicle power connection, allowing it to operate whenever the vehicle is running or powered.
What is the difference between the B2 device and the Car device?
The B2 room device is designed for fixed indoor environments with broader coverage and wall/ceiling mounting, while the car device is optimized for smaller enclosed spaces, vibration tolerance, lower power draw, and vehicle-specific airflow patterns.

I don’t use the same vehicle all the time — is there a way I can easily transfer the FarUVC car device?
Yes. Vehicle units are usually designed with removable mounts or brackets so the device can be unclipped and reattached to another compatible mounting point, making it practical to transfer between vehicles.
Where can I find more information about MySoter products?
For detailed specifications, installation guidance, safety certifications, and research references, the best source is the official MySoter website or authorised distributors, who can provide up-to-date documentation and technical support.
TEL:+86-755-23716085
E-mail: info@my-lumens.com
Facebook:@MYLUMENSGROUP
Twitter:@_MYLUMENS
LinkedIn:MY LUMENS TECHNOLOGY
MySoter FarUVC B2 Pro Manual:
Check out our Mysoter FarUVC products
MySoter - UV-Car222
$2,280.00
Features: 1.Easy installation. Shockproof, with extra silicone corner protectors, which is safe to riders.2. 45 degree Rotatable , adjust to the angle desired.3.Compared with UV254nm, no harm to eyes and skin4. 10000Hrs lifespan. After 3000Hrs running, <10% light degradation.5. Kills all known… read more
MySoter - UV-Pro222-B2
$2,280.00
Features: 1.Portable and Easy installation2. Compared with UV254nm, no harm to eyes and skins.3.10000Hrs lifespan. After 3000Hrs running, <10% light degradation.4. Kills all known viruses and bacteria, e.g. COVID, SARS-CoV-2, Clostridium difficile.5. The whole machine is made of safe materials (non-mercury… read more
FAQs
What is FarUVC 222 nm?
FarUVC 222 nm is a specific wavelength of ultraviolet light produced by filtered excimer lamps. Unlike traditional germicidal UV, it has very limited penetration in biological tissue, which allows it to inactivate microbes while remaining suitable for use in occupied indoor environments when properly designed and certified.